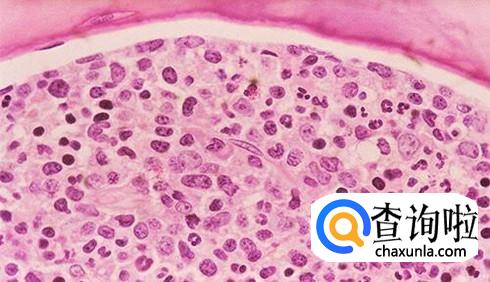

最佳回答
本文由作者推荐
详细内容
- 01
人是什么血型是根据骨髓来决定的,也就是说骨髓决定了血型是什么,一定程度上就可以说骨髓和血型的关系是密不可分的。

- 02
但是在相应的临床医学研究上,也存在部分不同血型进行骨髓移植的病例,并且在进行骨髓移植手术之后,人的血型也就发生了改变。

- 03
但是这个问题是说不清的,不同的人各个器官系统的能力都是不同的,也许别人能够适应不同的骨髓,但是如果你这样操作的话,可能身体就会出现病症了。
- 04
所以,如果涉及到需要进行配型问题的时候,建议咨询相应的专业医生,这个问题需要考虑的方面是比较多的,而且有的人也书血型和骨髓类型(造血干细胞HLA分型)没有关系。

广告位
点击排行
- 2 排行
- 3 排行
- 4 排行
- 5 排行
- 6 排行
- 7 排行
- 8 排行
- 9 排行
- 10 排行
热点追踪
广告位





















